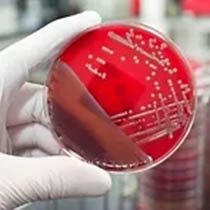

Slide 2
Growing with the best lab products
Slide 2


Slide 2
A guarantee of 100% quality
Slide 2


Slide 2
Leading you to better health
BOOK A HOME COLLECTION
Health Profile
Our Services
Facing a Health Issue? Let us Help.
Select a body organ and we’ll suggest the best available tests to help in precise diagnosis of the problem.